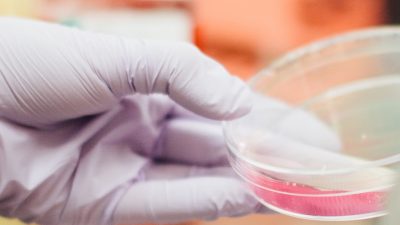

Your postgrad bucket list
Congratulations, you made it to uni! This is a really exciting time but – take our word for it – it’ll absolutely fly by, especially if you’re only here for a year. It can seem like there’s so much to do and so little time to do it, but don’t let that overwhelm you. We’ve […]